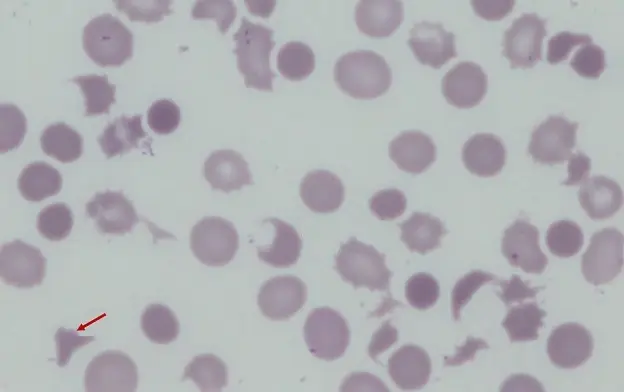
圖片

115年:(醫檢)血液(1)
圖示為Liu's stain 的周邊血液抹片,箭號所指的是何種細胞?
Aacanthocyte
Bsickle cell
Cblister cell
Dschistocyte (fragmented RBC )
詳細解析
本題觀念:
本題考查的是紅血球形態學 (RBC Morphology) 的判讀,特別是針對紅血球碎片 (Fragmented RBCs) 的辨識。這類細胞形態通常與紅血球受到機械性破壞 (Mechanical damage) 有關,是臨床上診斷微血管病性溶血性貧血 (Microangiopathic Hemolytic Anemia, MAHA) 的重要依據。
影像分析:
-
目標細胞 (紅色箭頭):
- 箭頭所指的細胞明顯比周圍正常的紅血球小。
- 呈現不規則的形狀,具體為三角形 (triangular) 或 頭盔狀 (helmet-shaped)。
- 邊緣銳利,且缺乏正常紅血球的中間蒼白區 (central pallor),顯示其為細胞膜受損後濃縮的碎片。
- 這是一個典型的裂細胞 (Schistocyte)。
-
背景細胞:
- 視野中可見紅血球大小不一 (Anisocytosis)。
- 周圍亦可見其他形狀異常的細胞,顯示病人可能處於溶血或紅血球破壞的病理狀態。
選項分析:
-
A. Acanthocyte (棘細胞 / Spur cell):
- 特徵:這是一種完整的紅血球,表面帶有不規則分佈、長度與粗細不一的突起 (spicules)。細胞通常較小且濃染,無中間蒼白區。
- 鑑別:棘細胞是「整顆細胞」變形,而箭頭所指為「細胞碎片」。棘細胞常見於嚴重肝病或無 β-脂蛋白血症 (Abetalipoproteinemia)。
- 結論:與圖像不符。
-
B. Sickle cell (鐮刀多角形細胞 / Drepanocyte):
- 特徵:紅血球呈現細長的新月形 (crescent) 或鐮刀狀,兩端尖細。這是由於血紅素 S (HbS) 聚合所致。
- 鑑別:鐮刀形細胞線條較為流暢,呈現兩端尖的長條狀;而圖中細胞為邊緣銳利的三角形碎片。
- 結論:與圖像不符。
-
C. Blister cell (水泡細胞):
- 特徵:紅血球邊緣有一個偏心的空泡 (vacuole),看起來像皮膚上的水泡。這是氧化壓力 (如 G6PD 缺乏症) 造成海因茲氏體 (Heinz bodies) 被脾臟移除過程中的過渡形態。
- 鑑別:水泡破裂後雖然可能形成類似頭盔狀的細胞 (Bite cell / Keratocyte),但 "Blister cell" 特指帶有空泡的階段。圖中細胞無空泡,是明顯的碎片。
- 結論:與圖像不符。
-
D. Schistocyte (Fragmented RBC / 裂細胞):
- 特徵:這是紅血球受到機械性剪力破壞後形成的碎片。形狀多變,常見三角形、頭盔形 (Helmet cell)、逗號狀或不規則碎片。通常無中間蒼白區。
- 原因:常見於 DIC (瀰漫性血管內凝血)、TTP (血栓性血小板低下紫斑症)、HUS (溶血性尿毒症候群) 或人工瓣膜造成的溶血。
- 結論:圖像中箭頭所指的細胞具備典型的三角形碎片特徵,完全符合 Schistocyte 的定義。
答案解析:
圖中紅色箭頭所指的細胞呈現三角形、邊緣銳利,且體積明顯小於正常紅血球,缺乏中央蒼白區。這是紅血球在微血管中受到纖維蛋白絲 (fibrin strands) 切割或機械性外力破壞後殘留的碎片。這種形態學特徵在血液學中被定義為 Schistocyte (裂細胞) 或 Fragmented RBC。因此,正確答案為 (D)。
核心知識點:
- Schistocyte (裂細胞):
- 定義:機械性破壞造成的紅血球碎片。
- 形態:三角形、頭盔形 (Helmet cells)、新月形碎片,通常比正常 RBC 小,無 Central pallor。
- 臨床意義:提示微血管病性溶血性貧血 (MAHA),如 TTP (需緊急血漿置換)、HUS、DIC、HELLP syndrome 或嚴重燒傷。
- 危急值:在周邊血液抹片中出現 Schistocyte 通常是危急訊號,需立即通報臨床醫師評估是否為血栓性微血管病變。
參考資料
- Rodak's Hematology: Clinical Principles and Applications.
- ICSH recommendations for identification, diagnostic value, and quantitation of schistocytes. International Journal of Laboratory Hematology.